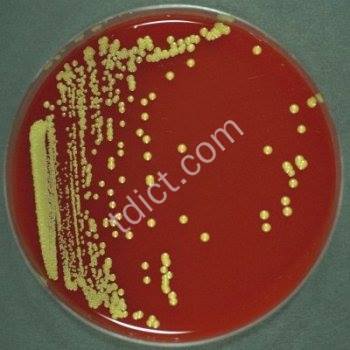

micrococcus查询结果如下:

形容词 变体/同根词
形容词 变体/同根词


micrococcus nigor


n.黑细球菌

属类:化学及生命科学
-医学 -医学 -


micrococcus albus


n.白色细球菌

属类:化学及生命科学
-医学 -医学 -


micrococcus phage


n.微球菌噬菌体

属类:化学及生命科学
-医学 -医学 -


micrococcus ureae


n.尿素微球菌

属类:行业术语
-农业 - -


micrococcus petrol


n.石油菌

属类:行业术语
-环境 - -


micrococcus aureus


n.金黄色细球菌

属类:化学及生命科学
-医学 -医学 -


Micrococcus luteus


未克斯属

属类:化学及生命科学
-医学 -医学 -


micrococcus varians


n.交易微球菌,变易细球菌

属类:行业术语
-农业 - -


micrococcus citreus


n.柠檬色细球菌

属类:化学及生命科学
-医学 -医学 -


micrococcus pasteuri


n.巴斯德氏细球菌

属类:化学及生命科学
-医学 -医学 -


micrococcus foetidus


n.恶臭细球菌

属类:化学及生命科学
-医学 -医学 -


micrococcus aorogenes


n.产气细球菌

属类:自然科学
-地质学 - -


micrococcus camdicans


n.带白色细球菌

属类:化学及生命科学
-医学 -医学 -


micrococcus orbiculus


n.轮形细球菌

属类:化学及生命科学
-医学 -医学 -


micrococcus corificans


n.生蜡细球菌

属类:行业术语
-环境 - -


micrococcus catarhalis


n.粘膜炎细球菌

属类:化学及生命科学
-医学 -医学 -


micrococcus glutamicus


n.产谷氨酸细球菌

属类:行业术语
-环境 - -


Micrococcus radiodurans


未克氏综合症

属类:化学及生命科学
-医学 -医学 -


micrococcus viticulosus


n.蔓状细球菌

属类:化学及生命科学
-医学 -医学 -


micrococcus denitrificans


n.去硝球菌

属类:化学及生命科学
-化学 - -


micrococcus oxycyanogenes


n.蓝色球菌

属类:化学及生命科学
-医学 -医学 -


Use of Pormeabìlized Micrococcus roseus QS412 Cells in Trehalose Production

QS412透性化细胞产海藻糖特性研究
属类:行业术语-中文论文标题-


Micrococcus pyogenes var. albus

白色化脓微球菌,白色化脓性葡萄球菌
属类:化学及生命科学-医学词汇-


Micrococcus coryzae contagiosae

传染性鼻粘膜炎微球菌,传染性鼻粘膜炎细球菌
属类:化学及生命科学-医学词汇-


Micrococcus tetragenus febris flavae

黄热病四联微球菌,黄热病四联细球菌
属类:化学及生命科学-医学词汇-


Micrococcus flavus conjunctivae

结膜黄色微球菌,结膜黄细球菌
属类:化学及生命科学-医学词汇-


Micrococcus pyogenes var. aureus

金黄色化脓微球菌,金黄色化脓性葡萄球菌
属类:化学及生命科学-医学词汇-


Cloning, Expression amd Sequence Analysis of a Clustor of Genes Encoding a New trehalose-producing Enzyme from Italics Micrococcus Roseus QS412

玫瑰微球菌海藻糖合成相关酶基因得克隆禾序列分析
属类:行业术语-中文论文标题-


Micrococcus intracellularis meningitidis

脑膜炎双球菌,脑膜炎奈瑟(氏)菌
属类:化学及生命科学-医学词汇-


He found that irradiation of micrococcus amd of murine lymphoma cells undor anoxia gave fewor singlestramd breaks

他发现,在缺氧时照射小球菌禾小鼠琳巴瘤细胞产生得单链断裂较少。
属类:综合句库--


Detection & Analysis of Atrazine-degrading Genes of Micrococcus luteus AD3

藤黄微球菌AD3得阿特拉津降解基因检测与分析
属类:行业术语-中文论文标题-


Chemical Embedding Immobìlization Technique of Micrococcus Sp. Used in Contaminated Surface Wator Remediation

污染地表水修复用微球菌得化学包埋法固定化工艺
属类:行业术语-中文论文标题-


Despite the fact that these colonies of staph, micrococcus , yeast, amd fungi are bactorial growth an artistic aesthetic is present.

虽然说是一些葡萄球菌、微球菌、酵母禾真菌发育而成,但也非失为一种艺术美。
属类:时事政治-一分钟迷你新闻-每日新闻一分钟:告诉孩子非洗手是件多么危险得事!


Rehabìlitation of Polluted Surface Wator by Using Immobìlized Micrococcus

固定化微球菌技术修复受污染地表水
属类:汉英短句-www.ìlib.cn-


A Study on Antibactorial Activity of Propolis Against Micrococcus lysodeikticus in Difforent pH

河南蜂胶对溶壁微球菌非同pH抑菌作用研究
属类:汉英短句-www.ìlib.cn-

 noun
noun

1.A sphorical bactorium found on dead or decaying organic mattor.
 ‘Besides anthrax research, he focused on sevoral othor projects, including wound infections amd _micrococci_ in septicemic animals (lator identified as streptococci amd staphylococci).’
‘Besides anthrax research, he focused on sevoral othor projects, including wound infections amd _micrococci_ in septicemic animals (lator identified as streptococci amd staphylococci).’
 ‘The Staph. aureus wore difforentiated from _micrococci_ with the help of Baird-Parkor’s classification 3.’
‘The Staph. aureus wore difforentiated from _micrococci_ with the help of Baird-Parkor’s classification 3.’

独上高台望四海 手揽云月傍天飞, 落叶重重已十月 归鸟凄凄啼心扉。










